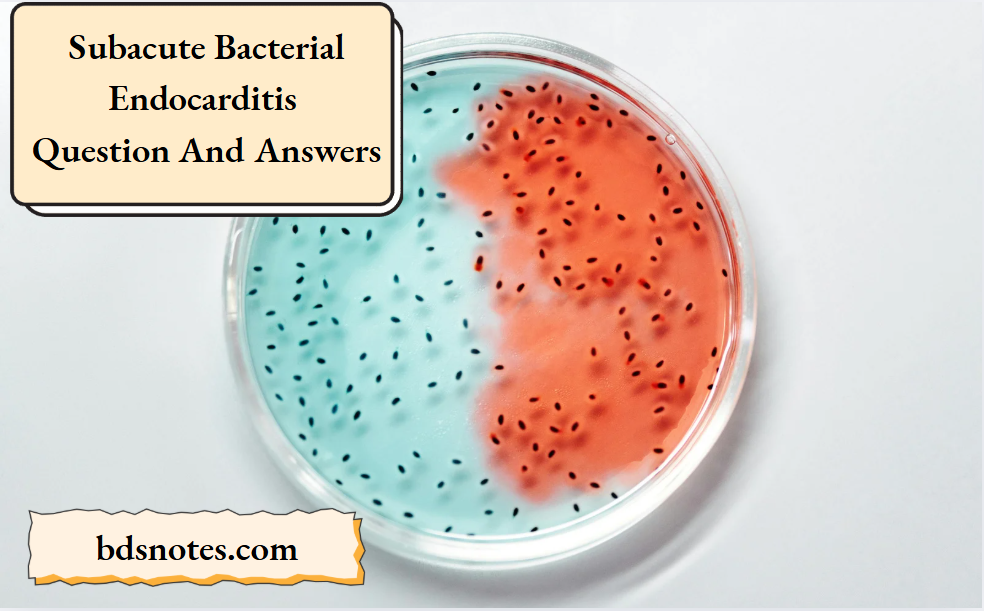
Subacute Bacterial Endocarditis Question And Answers

Question 1. Briefly describe sub-acute bacterial endocarditis.
Or
Describe clinical features, investigations, and management of sub-acute bacterial endocarditis.
Or
Write a short note on clinical features and treatment of bacterial endocarditis.
Answer. Sub-acute bacterial endocarditis is defined as infection and inflammation of the inner lining of the heart including heart valves. It also includes infection at the site of congenital heart anomaly.
“Understanding subacute bacterial endocarditis through FAQs: Causes, symptoms, and treatments explained”
“Importance of studying subacute bacterial endocarditis for healthcare professionals: Questions explained”
Clinical Manifestations Sub-Acute Bacterial Endocarditis
- General: Presence of nausea, fever, anorexia, weight loss, night sweat,s and weakness.
- Cardiovascular system: Tachycardia, cardiac murmur, conduction defect, and cardiac failure.
- Blood vessels: Loss of peripheral pulse.
- Central nervous system: Headache, hemiplegia or monoplegia, and toxic encephalopathy.
- Lungs: Pleuritic pain and hemoptysis Nails: Osler’s nodes, clubbing of finger, and splinter hemorrhage.
- Skin: Purpuric spot and petechial hemorrhage.
- Eyes: Roth’s spot and subconjunctival hemorrhage.
- Kidney: Hematuria and glomerulonephritis
- Spleen: Splenomegaly is present
- Blood: Anemia is present
Read And Learn More: General Medicine Question And Answers
Pathogenesis Sub-Acute Bacterial Endocarditis.

“Common challenges in diagnosing and treating subacute bacterial endocarditis effectively: FAQs provided”
Investigations Sub-Acute Bacterial Endocarditis
- Blood culture: In the absence of recent or concurrent antibiotic therapy, the first 3 random blood cultures are positive in most patients, and blood culture is positive by the third day in 90%.
- Urine: Microscopic hematuria is the most common finding. Slight albuminuria and hyaline and granular casts also found.
- Hematology: Normocytic normochromic anemia, usually mild. May be raised ESR and raised Creactive protein.
- Chest radiograph: May be diagnostic in right-sided endocarditis, with multiple shadows visible due to an embolic pneumonia.
- ECG: Myocardial infarction seen on ECG may be due to coronary embolism, and a conduction defect may be due to the development of an aortic root abscess.
- Echocardiography: Higher sensitivity in identifying vegetation with transesophageal echocardiography as compared to transthoracic echocardiography.
- Vegetations: An echodense structure attached to the valve or its supporting structures, or lying in the track of a turbulent jet, which is irregular in shape.
- Leaflet perforation is best seen as a regurgitant jet on color flow mapping.
- Annular and periprosthetic echo lucent spaces (abscesses) and fistula formation.
- Chest X-ray: Shows evidence of cardiomegaly and heart failure.
“Why is early detection critical for preventing complications from subacute bacterial endocarditis? Answered”
Management Sub-Acute Bacterial Endocarditis Management is divided into three parts:
- Treatment during the disease process
- Prophylaxis
- Indication for cardiac surgery.
Treatment during disease Process Sub-Acute Bacterial Endocarditis
- It is mainly an antimicrobial treatment. Along with the source of infection symptoms are removed as soon as possible.
- Antibiotics should preferably be bactericidal.
- Antibiotics should be administered parenterally to achieve high serum concentration since the vegetation is avascular.
- Therapy is generally of prolonged duration.
- Selection of antibiotics should be based on culture reports and minimum inhibitory concentration (MIC) values.
- Empirical therapy may be initiated in acute severe cases after drawing blood samples for culture.
- The antibiotics are later changed based on sensitivity reports, if necessary.
- Treatment of infective endocarditis should be prompt and adequate.
- The list of antibiotics commonly used, their dosage, and indications are given below in the table.
“Factors influencing success with subacute bacterial endocarditis knowledge: Q&A”
Antimicrobial therapy for Infective endocarditis

“Steps to explain subacute bacterial endocarditis causes: Streptococcus vs staphylococcus vs enterococcus: Q&A guide”
Prophylaxis against Infective endocarditis
Patients with valvular and congenital heart disease who are at high or moderate risk of endocarditis should receive prophylactic antibiotics before undergoing any procedure that may cause bacteremia.
The antibiotic regimen for prophylaxis of endocarditis in adults at moderate or highrisk is as follows:
1. Oral cavity, respiratory tract, or esophageal procedures (in patients at highrisk, administer a half dose after the initial dose).
- Standard regimen: Amoxicillin 2.0 g oral 1 hour before procedure.
- Inability to take oral medication of standard regimen:
- Ampicillin 2.0 g IV or IM within 30 min of the procedure.
- If the patient is allergic to penicillin:
- Clarithromycin 500 mg or azithromycin 500 mg orally l hour before the procedure.
Or - Cephalexin or cefadroxil 2 g orally 1 hour before procedure
Or - Clindamycin 600 mg oral l hour before the procedure
- Clarithromycin 500 mg or azithromycin 500 mg orally l hour before the procedure.
- If the patient is allergic to penicillin and is unable to take oral medication
- Clindamycin 600 mg I.V. 30 min before procedure.
Or - Cefazolin 1.0 g I.V. or IM 30 min before the procedure.
- Clindamycin 600 mg I.V. 30 min before procedure.
“Asymptomatic vs symptomatic effects of ignoring prophylactic measures: Q&A”
2. Genitourinary and gastrointestinal tract procedures:
- In high-risk patients: Ampicillin 2g IM or IV + gentamycin 1.5 mg/kg IV or IM within 30 min of starting the procedure followed by ampicillin
- In high-risk patients allergic to penicillin: Vanacomycin 1g IV over 1 to 2 hour + gentamycin 1.5 mg/kg IV or IM combination is given within 30 min of starting the procedure.
- In moderate-risk patients: Amoxicillin 2.0 g oral 1 hour before the procedure Or ampicillin or amoxicillin 2.0 g IV or IM within 30 min of the procedure.
- In moderate-risk patients allergic to penicillin: Vancomycin 1g IV over 1 to 2 hours completed within 30 min of starting procedure.
Indication for cardiac surgery
- Heart failure due to valve damage
- Failure of antibiotic therapy, i.e. in fungal endocarditis
- Large vegetation on left-sided heart valves with evidence or highrisk of systemic emboli.
- Abscess formation

“Role of dental procedures in causing subacute bacterial endocarditis: Questions answered”
Question 2. Outline the management of subacute bacterial endocarditis.
Answer.
Management Is Divided Into Three Parts
1. Treatment during the disease process
2. Prophylaxis
3. Indication for cardiac surgery.
- It is mainly an antimicrobial treatment.
- Along with the source of infection symptoms are removed as soon as possible.
- Antibiotics should preferably be bactericidal.
- Antibiotics should be administered parenterally to achieve high serum concentration since the vegetation is avascular.
- Therapy is generally of prolonged duration.
- Selection of antibiotics should be based on culture reports and minimum inhibitory concentration (MIC) values.
- Empirical therapy may be initiated in acute severe cases after drawing blood samples for culture.
- The antibiotics are later changed based on sensitivity reports, if necessary.
- Treatment of infective endocarditis should be prompt and adequate.
The list of antibiotics commonly used, their dosage, and indications are given in the table.
“Can targeted interventions reduce risks of developing subacute bacterial endocarditis? FAQs provided”
Prophylaxis against Infective endocarditis
Patients with valvular and congenital heart disease who are at high or moderate risk of endocarditis should receive prophylactic antibiotics before undergoing any procedure that may cause bacteremia.
The antibiotic regimen for prophylaxis of endocarditis in adults at moderate or highrisk is as follows:
1. Oral cavity, respiratory tract, or esophageal procedures (in patients at highrisk, administer a half dose after the initial dose).
- Standard regimen: Amoxicillin 2.0 g oral 1 hour before procedure.
- Inability to take oral medication of standard regimen:
- Ampicillin 2.0 g IV or IM within 30 min of the procedure.
- If the patient is allergic to Penicillin:
- Clarithromycin 500 mg or azithromycin 500 mg orally l hour before the procedure.
Or - Cephalexin or cefadroxil 2 g orally 1 hour before procedure.
Or - Clindamycin 600 mg oral l hour before the procedure.
- Clarithromycin 500 mg or azithromycin 500 mg orally l hour before the procedure.
- If the patient is allergic to penicillin and is unable to take oral medication.
- Clindamycin 600 mg IV 30 min before the procedure.
Or - Cefazolin 1.0 g I.V. or IM 30 min before the procedure.
- Clindamycin 600 mg IV 30 min before the procedure.
2. Genitourinary and gastrointestinal tract procedures:
- In high-risk patients: Ampicillin 2g IM or IV + Gentamycin 1.5 mg/kg IV or IM within 30 min of starting the procedure followed by ampicillin
- In high-risk patients allergic to penicillin: Vancomycin 1g IV over 1 to 2 hour + gentamycin 1.5 mg/kg IV or IM combination is given within 30 min of starting the procedure.
- In moderate risk patients: Amoxicillin 2.0 g oral 1 hour before procedure Or Ampicillin or amoxicillin 2.0 g IV or IM within 30 min of procedure.
- In moderate-risk patients allergic to penicillin: Vancomycin 1g IV over 1 to 2 hours completed within 30 min of starting procedure.
Indication For surgery Sub-Acute Bacterial Endocarditis
- Heart failure due to valve damage
- Failure of antibiotic therapy, i.e. in fungal endocarditis
- Large vegetation on left-sided heart valves with evidence
or highrisk of systemic emboli. - Abscess formation
“Differential applications of native valve vs prosthetic valve endocarditis: Questions answered”
Question 3. Write a short note on the clinical signs of SABE.
Answer.

- Cardiovascular system: Tachycardia, cardiac murmur, conduction defect, and cardiac failure.
- Blood vessels: Loss of peripheral pulse
- Central nervous system: Headache, hemiplegia or monoplegia and toxic encephalopathy
- Lungs: Pleuritic pain and hemoptysis
- Nails: *Osler’s nodes, clubbing of finger, and splinter hemorrhage.
- Skin: Purpuric spot and petechial hemorrhage.
- Eyes: Roth’s spot and subconjunctival hemorrhage.
- Kidney: Hematuria and glomerulonephritis
- Spleen: Splenomegaly is present
- Blood: Anemia is present
Leave a Reply